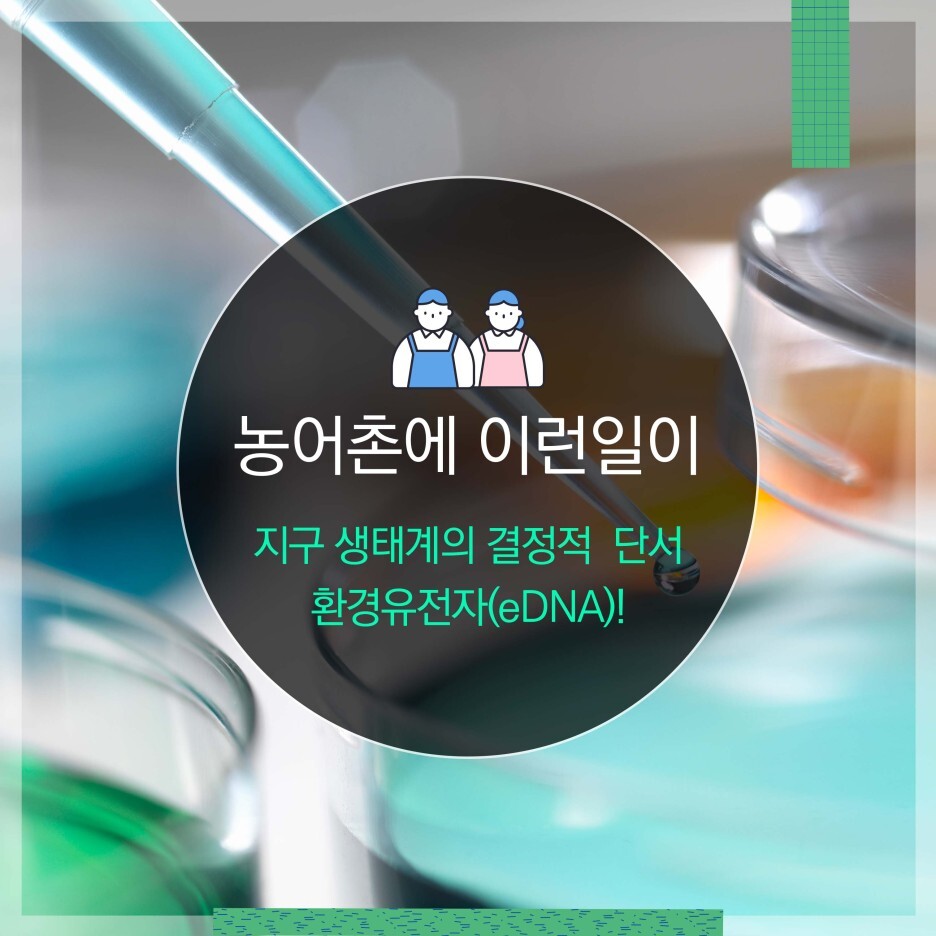

탐정만화나 영화를 보면 단골처럼 등장하는 용어가 있습니다.
바로 세포의 핵 안에 존재하는 유전자 물질, DNA인데요.
DNA는 이 세상에 딱 하나뿐인 유전자 물질이라 모든 생물의 특성을 결정짓는 정보가 됩니다.
보통 유기체에만 DNA가 있다고 알고 있지만,
유기체가 아닌 우리가 살고 있는 환경에도 DNA가 있다고 해요.
바로 eDNA, 환경유전자 이야기입니다!
지금부터 eDNA, 환경유전자에 대해 함께 알아보아요-!
eDNA, 환경유전자란?

eDNA는 Environment DNA의 줄임말로 번역하면 환경유전자라는 말입니다. 말 그대로 환경 속에 남겨진 유전정보라는 뜻인데요. 물이나 흙, 공기 등 환경 속에 남겨진 생명체의 점액과 피부 조직, 배설물 등을 활용해 환경 생태를 살피는 활동을 말합니다. eDNA는 사람이 직접 접근하기 어려운 환경에 사는 생물의 생태계를 파악하는데 굉장히 중요한 역할을 해요. 지금까지 사람이 접근하기 어려운 심해나 절벽의 생태계는 확인할 방법이 없어 미지의 세계로 남아있었거든요. 하지만 eDNA 기술이 있으면 천혜의 환경에 감춰진 생태계도 쉽게 확인할 수 있습니다. 사람이 아니라 장비를 사용해 환경에 남아있는 DNA만 확인하면 되기 때문이죠.
eDNA가 각광받는 이유?

쉽게 예를 들어 설명해 볼까요? 심해 깊은 곳에 사는 멸종위기종이 있습니다. 이 생물의 생태를 연구해야 하지만 심해에 사람이 직접 들어가기 위해서는 수많은 장비와 시간이 필요한데요. eDNA를 활용하면 이 과정이 상당히 단축됩니다. 심해의 물을 일정량 퍼서 그 안에 담긴 생물체의 점액과 피부 조직 등을 관찰하면 되거든요. 생물과 직접 접촉하지 않아서 생물에게 스트레스도 주지 않고, 심해에 접근하는 과정에서 발생하는 자본과 시간도 절약할 수 있습니다. 완벽해 보이는 eDNA 기술이지만, 단점도 있어요. 바로 eDNA 값이 상대적인 양으로 표현되어 오차가 일어날 수 있다는 겁니다. 같은 지역에서 채취한 eDNA라도 지역에 따라, 혹은 채취한 장소 주변의 환경에 따라 값이 천차만별로 달라질 수 있어요. 그래서 남해안처럼 양식장이 많은 곳에서는 eDNA를 제대로 활용하기 어렵습니다. 양식장에서 유실되는 사료로 인해 오차가 생길 가능성이 크거든요.
전 세계에서 활용되고 있는 eDNA 기술들!

eDNA 기술은 현재 세계 각국에서 실제로 활용되고 있는 기술이에요. 아직까지는 육지나 강, 얕은 바다에서만 사용되고 있지만, 기술이 발전하면서 점차 심해와 절벽처럼 접근이 어려운 곳에서도 eDNA가 사용되고 있습니다. 미국 지질조사국에서는 eDNA 검사법을 통해 물속에 녹아있는 바다소(해우)들의 DNA를 검출, 바다소의 개체군과 이동경로를 파악했다고 해요. 캘리포니아에서도 eDNA를 사용해 백상아리의 출몰을 미리 예측하는 프로그램이 진행된 바 있습니다. 나아가 한국에서도 eDNA는 활발하게 사용되고 있어요. DMZ 등 민간인의 출입이 제한된 비무장지대에서는 eDNA를 채취해 멸종위기종의 서식을 확인하는 작업이 이어지고 있습니다. 해양자원의 보고로 알려진 독도에서도 eDNA가 사용되고 있습니다. 해양수산부 국립수산과학원은 독도해역의 eDNA를 통해 지금까지 직접 잠수해서 확인한 18종외에 46종의 해양생물의 서식 가능성을 파악해 화제가 되기도 했습니다.
지구와 자연에는 아직까지 무궁무진한 비밀이 숨겨져 있습니다.
eDNA 기술은 지금까지 인간이 접근하지 못했던
비밀스러운 지구 생태계에 접근할 수 있는 새로운 연구방법이에요.
eDNA를 필두로 점점 발전하는 연구들이
언젠가 지구의 비밀을 모두 파헤칠 수 있을까요?

[참고자료]
한국해양과학기술원, 환경 속에 생물의 흔적이 있다! 바닷속 증거물 eDNA
https://blog.naver.com/kordipr/222477659638
해양수산부, 이건 팝콘각! ‘명탐정 eDNA_바다의 추적자’
https://blog.naver.com/koreamof/222533413312
에코타임스, 환경유전자(eDNA)
http://www.ecotiger.co.kr/news/articleView.html?idxno=31820
서울신문, [요즘 과학 따라잡기] 과학수사와 비슷한 해양연구/김성 한국해양과학기술원 책임연구원
https://www.seoul.co.kr/news/newsView.php?id=20210907029016&wlog_tag3=naver
국립생태원, 환경디엔에이(eDNA) 분석을 통해 비무장지대 멸종위기 어류 서식 확인!
https://blog.naver.com/nie_korea/222065939404
'농어촌에 풍덩' 카테고리의 다른 글
| [농어촌에 풍덩?] 중국산이 국산으로?! 설 선물&제수용 농식품원산지 구분 방법! (0) | 2022.01.31 |
|---|---|
| [농어촌에 풍덩?] 만약에 김치가 없었더라면~? 지역별 김치 알아보기? (0) | 2022.01.25 |
| [?KRC가 답하다] 오랫동안 시들지 않는 꽃처럼, 생기와 에너지 넘치는 마을로 나아가다! (0) | 2021.12.28 |
| [?농부일기] 청년농부 홍지성 씨의 추수하는 날 - 일 년 농사, 큰 결실로 완성되다! (0) | 2021.12.27 |
| [무엇이든 물어보롱!] 일상 속 농어촌 관련 루머 파헤치기 | EP5. 환절기 특집 감기 속설 모음 (0) | 2021.12.21 |